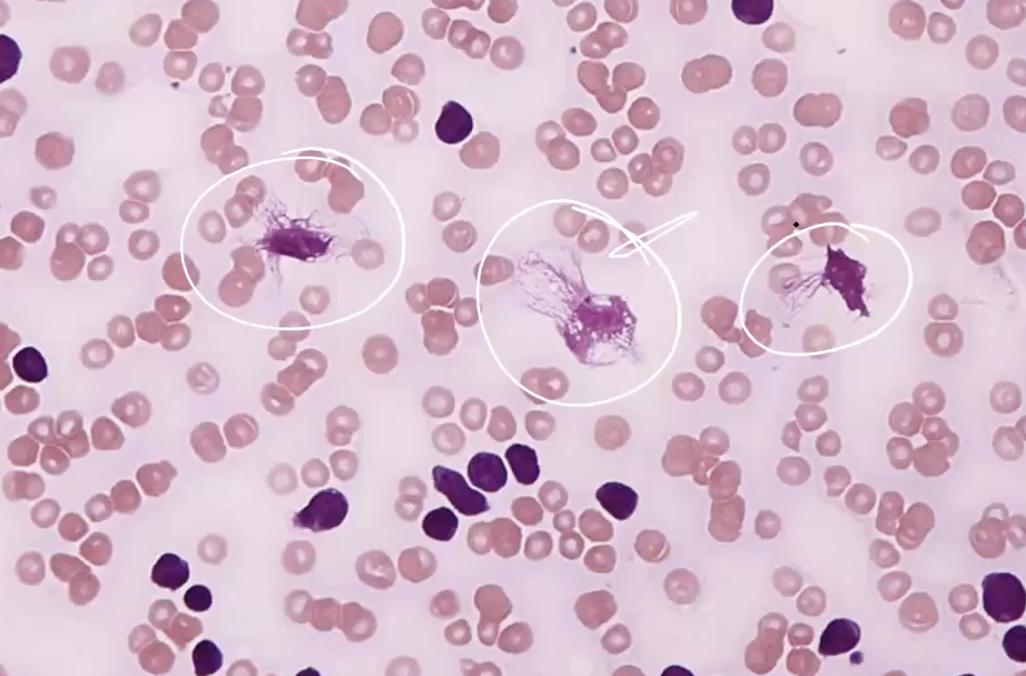
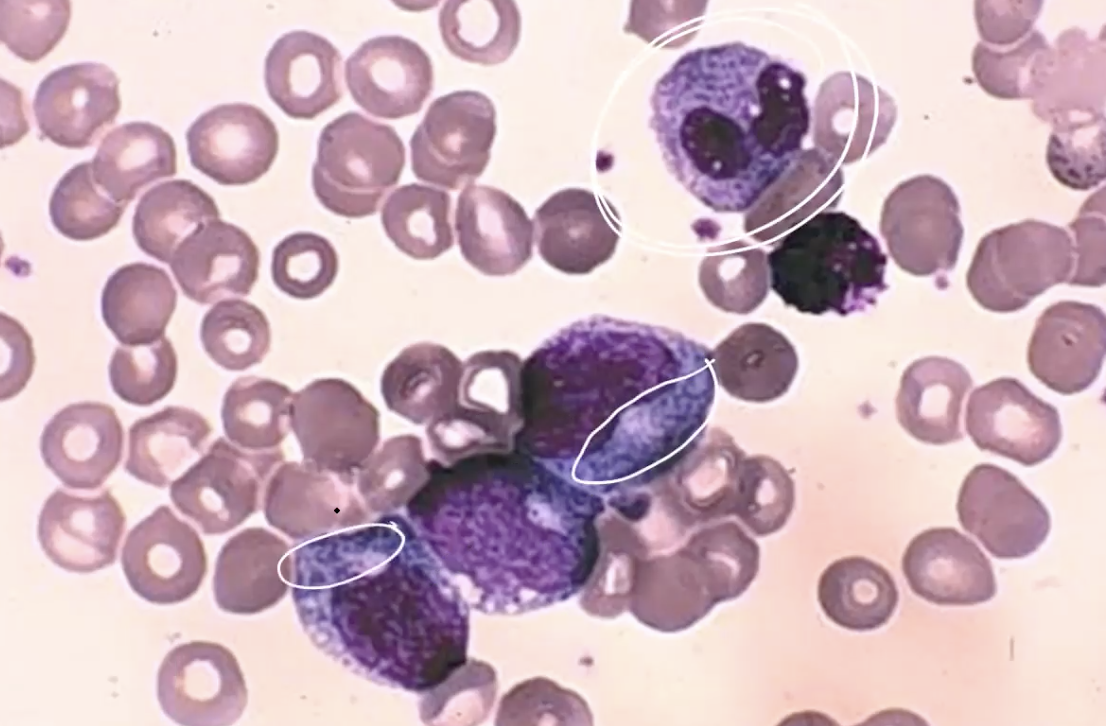
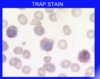

Most common leukemia of adults in the western world
Chronic Lymphocytic Leukemia
(70 y/o; M>F)

CD5+ on flow cytometry indicates ______
CLL. This is an aberrant marker (belongs to T cell)
(also CD19+/CD20+)

CLL is an accumulation of ____ cells
mature (not blastic) neoplastic lymphocytes (mostly B-cells)

CLL: “smudge cells” or “basket cells”
(made by making the slide)
Bone marrow failure seen in CLL will lead to _____ (3).
- thrombocytopenia → bleeding
- anemia
- neutropenia


Bone marrow bx: CLL
What does this tell you?

light chain restriction
In CLL, del ____ has an intermediate survival, while del ____ has the poorest.
- 11q → DNA repair mutation
- 17p → p53 loss
In T-cell CLL, del _____ has extensive lymph node involvement and is aggressive.
11q22 → ATM deletion

Unlike B-cell Malignant lymphoma, B-cell CLL manifests as a high expression of _____.
BCL-2 on 18q21 (anti-apoptotic protein→ maintains neoplastic cells)
(this is a different mechanism than some of the lymphomas)

In CLL, loss of the tumor suppression is especially prolific in the proliferation centers where tumor cells receive signals for growth and survival through the ______.
Bruton Tyrosine Kinase (BTK)
B-cell CLL has mutations in the ______ chain of the VH gene complex
heavy or light
(markers for the VH gene complex are CD38 & ZAP-70)
How do we monitor the minimal residual disease (MRD) of leukemias?
cytogenetic screening of marrow or blood
Median survival for CLL is ______ w/low tumor burden
4-6 years

Lymph node biopsy of CLL will show diffuse effacement by an infiltrate of ______ & proliferation centers (mixed large lymphocytes & loose aggregates)
small lymphocytes
Good prognosis: markers for the VH gene complex are CD38 & ZAP-70 are _____ (increased/decreased)
(Immature subtype of CLL)
decreased (means they are less mature)
(Mature sub-type does not have these at all → better prognosis)

AML
(below is normal bone marrow)

Like AML, CML has CD13+, CD33+, but in opposition to AML, CML is ______ (-).
CD45RA
(also CML has a philadelphia chromosome - short 22)

CML lab findings include immature myelocytic cells as well as elevated ______ (2 cell types).
- basophils
- eosinophils

How can you tell if a myeloblast is mature?
increased granulation in the cytoplasm

CML : mixture of mature cells

why is uric acid elevated in CML? What can this lead to?
- it is a metabolite of DNA (high cell turnover bc they are dying)
- oligoarticular arthritis (deposition)

______ is a unique is a risk factor for CML
Herbicide/pesticide exposure
In CML, lab findings include : elevated uric acid, ______(2).
- anemia
- high plts